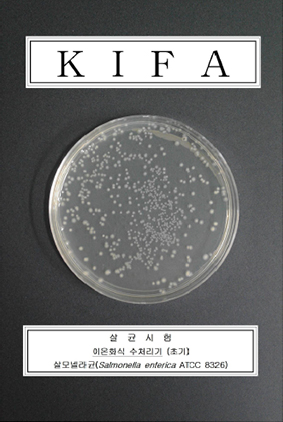
salmonella enterica E.coli remove rust scale sterilization iorex IOREX
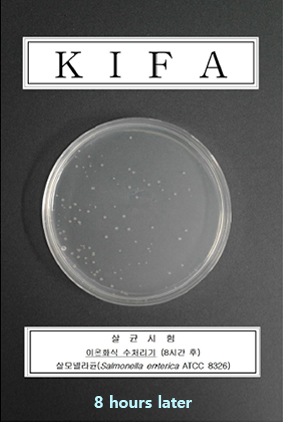
salmonella enterica E.coli remove rust scale sterilization iorex IOREX
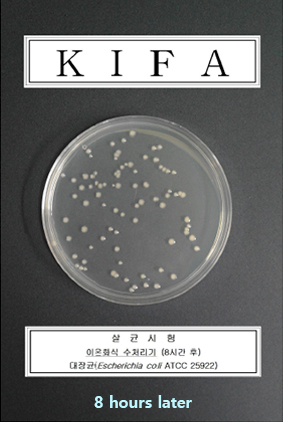
salmonella enterica E.coli remove rust scale sterilization iorex IOREX

Drinking good water is protecting your family. Reset Your Water How are you taking care of it?
IOREX manages the piping for water quality management.
 DRINKING
DRINKING BATHE
BATHE LAUNDRY
LAUNDRY KITCHEN
KITCHEN BOILER
BOILER GARDENING
GARDENING


Clean and safe water supply from the water purification plant to the home
Drinking good water is protecting your family. Reset Your Water How are you taking care of it?
IOREX manages the piping for water quality management.
 DRINKING
DRINKING BATHE
BATHE LAUNDRY
LAUNDRY KITCHEN
KITCHEN BOILER
BOILER GARDENING
GARDENING


IOREX is an innovative, zero-power,self-operating, and energy-neutral water and pipe treatment system that effectively removes and prevents rust and scale by instantly ionizing water as it passes through a water supply system.Your home’s water pipes are managed clean and healthy by IOREX from now on.

Please check NSF mark on IOREX device.

NSF/ANSI 61 – Drinking Water System Components : Health Effects
NSF/ANSI 372 – Drinking Water System Components : Lead Content
More than 300 items inspection in water qualtiy
Test under varying conditions as Ph5, 8, 10
Annual Sample Test
Annual Factory audit
Product reviewed to established standards



